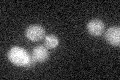
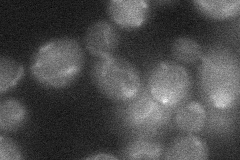

View description
Protein of unknown function; null mutant is viable but shows increased loss of mitochondrial genome and synthetic interaction with prohibitin (phb1); contains an intron
Localization:
Intensity:
Fold change:
Significance:
-
C’ GFP library in SD
below threshold16.74 -
N' NOP1pr-GFP in SD

punctate,mitochondria23.9843 -
N' TEF2pr-mCherry in SD

punctate11.4297 -
N' NATIVEpr-GFP in SD

below threshold14.0146 -
N' TEF2pr-VC and Cyto-VN in SD
below threshold25.3322 -
C’ GFP library in SD+DTT

cytosol15.760.94No -
C’ GFP library in SD+H2O2

cytosol15.580.93No -
C’ GFP library in Starvation Media

cytosol17.061.01No -
C’ GFP library on the background of Pup2-DaMP

below threshold -
C’ GFP library on the background of CCT mutant

below threshold16.83861.00558No
